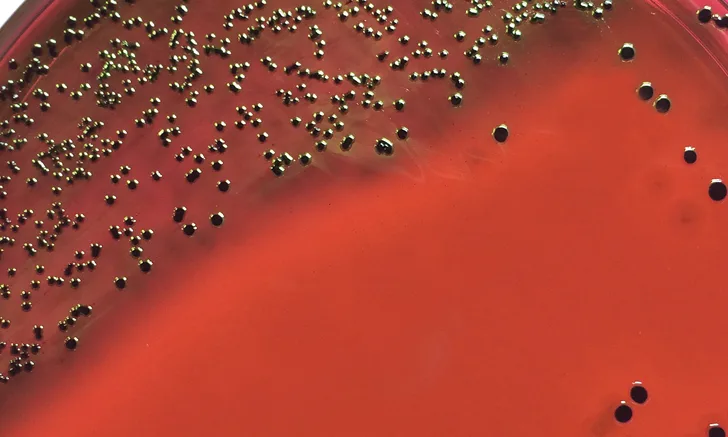

Top Urinary Tract & Prostate Antibiotics
Katrina R. Viviano, DVM, PhD, DACVIM, DACVCP, University of Wisconsin–Madison
Faye A. Hartmann, MS, MT (ASCP)S, University of Wisconsin–Madison
The gram-negative rod Escherichia coli, from the family Enterobacteriaceae, produces a green metallic sheen on eosin methylene blue (EMB) agar and is the most common bacterial pathogen associated with UTIs in companion animals and humans.
Bacteriuria (ie, presence of bacteria in urine) can arise in any segment of the urinary tract and can be complicated by concurrent problems. Species and anatomic differences may influence the site/origin of bacteriuria and, ultimately, the treatment approach (Figure).1-3

Initial empirical antimicrobial therapy for uncomplicated lower UTIs is guided by the predictability of the most likely uropathogens (Table 1 and Table 2).4,5 However, routine use of bacterial culture and antimicrobial susceptibility testing is recommended before antimicrobial therapy, especially in complicated cases.
Common Uropathogens Associated With Bacteriuria in Dogs & Cats


Note: Antimicrobial susceptibility can vary by region and facility as well as by whether antibiotics were previously administered. Antimicrobial susceptibility testing should be performed to help guide therapeutic decisions. Recommendations adapted from University of Wisconsin School of Veterinary Medicine yearly antibiograms and CLSI clinical use testing and efficacy recommendations.
Common Classes of Antibiotics used in Treating Bacteriuria in Dogs & Cats
β-lactams44,45
Volume of Distribution† 0.2-0.3 L/kg
Serum Half-Life† 0.5-5 hr
Protein Binding† 13%-26%
Recommended Dosages & Clinical & Laboratory Standards Institute UTI Susceptible Breakpoint Minimum Inhibitory Concentration (μg/mL)4,5
Potentiated Sulfonamides46
Volume of Distribution† 1.5/1 L/kg
Serum Half-Life† 2.5/9.8 hr
Protein Binding† 60%/15%-90%
Recommended Dosages & Clinical & Laboratory Standards Institute UTI Susceptible Breakpoint Minimum Inhibitory Concentration (μg/mL)4,5
Fluoroquinolones47
Volume of Distribution† 2-4 L/kg
Serum Half-Life† 4-9 hr
Protein Binding† 27%-30%
Recommended Dosages & Clinical & Laboratory Standards Institute UTI Susceptible Breakpoint Minimum Inhibitory Concentration (μg/mL)4,5
Tetracyclines27
Volume of Distribution† 1.5 L/kg
Serum Half-Life† 10-12 hr
Protein Binding† 80%
Recommended Dosages & Clinical & Laboratory Standards Institute UTI Susceptible Breakpoint Minimum Inhibitory Concentration (μg/mL)4,5
Amphenicols48-49
Volume of Distribution† 1.6 L/kg
Serum Half-Life† 2.4 hr
Protein Binding† 24%-55%
Recommended Dosages & Clinical & Laboratory Standards Institute UTI Susceptible Breakpoint Minimum Inhibitory Concentration (μg/mL)4,5
Nitrofurans39-50
Volume of Distribution† 0.46 L/kg
Serum Half-Life† 0.5 hr
Protein Binding† 20%-%
Recommended Dosages & Clinical & Laboratory Standards Institute UTI Susceptible Breakpoint Minimum Inhibitory Concentration (μg/mL)4,5
†Pharmacokinetic data reported is estimated for each antibiotic class based on available canine data.
aAmpicillin breakpoint, used to predict susceptibility to amoxicillin
bCephalothin breakpoint, used to predict susceptibility to cephalexin
cTrimethoprim-sulfamethoxazole breakpoint, used to predict susceptibility to trimethoprim-sulfadiazine
HHuman interpretive breakpoint where appropriate
SSkin/soft tissue veterinary interpretive breakpoint
SRSkin/respiratory veterinary interpretive breakpoint The authors recommendations for the common antibiotic classes used for treating clinical bacteriuria are outlined below.
1. β-Lactams
β-lactams are eliminated via renal mechanisms and achieve high urinary concentrations to effectively treat many common urinary pathogens (Table 3). Drug penetration into tissues (ie, prostate, kidney) is limited, as β-lactams are hydrophilic, weak organic acids with a low volume of distribution. Therefore, this drug class is not recommended for treating pyelonephritis or prostatic infections.
β-lactams are bactericidal with time-dependent pathogen killing. The pharmacodynamic parameter most predictive of clinical and bacteriologic efficacy is the time that drug serum concentrations are greater than the minimum inhibitory concentration (MIC) of the targeted pathogen; a minimum time greater than an MIC of 50% to 70% is recommended during the dosing interval.6
Adverse effects can include GI upset (ie, vomiting, diarrhea) and potential for hypersensitivity reactions. Of note, methicillin-resistant Staphylococcus aureus infections are resistant to all β-lactams.
Amoxicillin
For Enterobacteriaceae members, ampicillin is routinely used to predict amoxicillin susceptibility.
Amoxicillin requires frequent dosing; thus, its clinical use is limited if q8h dosing is not possible.
Amoxicillin–Clavulanic Acid
Clavulanic acid irreversibly binds β-lactamases, extending the spectrum of activity against β-lactamase–producing Staphylococcus spp and gram-negative bacteria (eg, Escherichia coli, Klebsiella spp, Proteus spp).
Cephalexin
Cephalexin is a first-generation cephalosporin with improved stability to β-lactamases relative to penicillins.
For members of Enterobacteriaceae, cephalothin is often used to predict cephalexin susceptibility. Enterobacteriaceae resistant to cephalexin may still be susceptible to cefazolin.
Cephalosporins are not clinically effective for treating enterococci, regardless of susceptibility results.
2. Potentiated Sulfonamides
Canine and feline urinary isolates often maintain greater than 90% susceptibility to trimethoprim-sulfonamides (TMP/sulfa).7 Short-duration therapy (ie, 3 days) of TMP/sulfa treatment may be effective in treating female dogs with uncomplicated UTIs.8 TMP/sulfa penetrates the blood–prostate barrier in part due to TMP becoming ion trapped (weak organic base) in the acidic (pH 6.4) prostatic tissue/fluid, which can result in prostatic concentrations equal to or greater than plasma concentrations.
Potentiated sulfonamides are not clinically effective in treating enterococci, regardless of susceptibility results.
There is potential for significant idiosyncratic hypersensitivity reactions in dogs (0.25%), including fever, hepatotoxicity, polyarthropathy, cutaneous drug eruptions, blood dyscrasias, uveitis, keratoconjunctivitis sicca, and/or proteinuria.9 Pretreatment CBC, serum chemistry profile, and Schirmer tear test should be considered, particularly if more than 3 days of TMP/sulfa treatment are anticipated and if patients develop clinical signs suggestive of an adverse reaction. Other reported adverse effects include crystalluria, anemia, and hypothyroidism.9
3. Fluoroquinolones
Fluoroquinolones (FQs) have excellent spectrum of activity against common gram-negative uropathogens. FQs are lipophilic, low protein-binding drugs with extensive tissue distribution. Prostatic concentrations are greater than or equal to serum concentrations.10
FQs provide concentration-dependent bacterial killing as well as a postantibiotic effect. To minimize toxicity and maintain efficacy, q24h dosing is recommended.10 The pharmacodynamic parameter most predictive of clinical and bacteriologic efficacy is the ratio of the 24-hour area under the curve to the MIC.6
FQs should be reserved for treating resistant infections, pyelonephritis, or prostatitis. Clinical cure rates of 87% have been reported following short-duration (ie, 3 days) enrofloxacin therapy in dogs with UTIs.11 FQs as a first-line therapy for uncomplicated UTIs should be avoided to minimize future antimicrobial resistance, as FQs are a second-tier (ie, voluntary restricted use) antibiotic class.
Higher antimicrobial resistance rates of urinary isolates occur in dogs treated with FQs in the past 30 days (28% susceptible) than in those that have not received antimicrobial therapy in the past 30 days (77% susceptible) or dogs previously treated with amoxicillin–clavulanic acid (74% susceptible).12
Oral absorption is decreased in the presence of di- and trivalent cations (eg, magnesium, aluminum, calcium).10 To maintain oral absorption, FQs should not be administered at the same time as other medications containing cations (eg, sucralfate,13 antacids containing aluminum or magnesium, phosphate binders).
Oral ciprofloxacin absorption is variable in dogs. In severe cases, recurrent infections, or cases in which treatment failure is suspected, a veterinary-labeled FQ is recommended. If ciprofloxacin use is unavoidable, the recommended dosage is 20-25 mg/kg PO q24h. Breaking or crushing tablets can improve bioavailability.14
In cats, side effects can include dose-dependent retinal degeneration and blindness.15 Feline populations at highest risk are those treated with high doses or overdoses of FQs, rapid IV infusions, and prolonged therapy as well as those with decreased glomerular filtration rate (eg, cats with chronic kidney disease or dehydration, geriatric cats).16-18
The risk for retinal degeneration in cats varies with the type of FQ. For example, no retinal changes have been reported for marbofloxacin at 20 times the label dose and pradofloxacin at 10 times the label dose, whereas retinal degeneration has been reported for enrofloxacin at 4 times the label dose.16-18
In cats with severe azotemia, FQ dose adjustment should be considered. An empirical recommendation based on concentration-dependent bacterial killing of FQs includes prolonging the dosing interval from q24h to q48h.
FQs have been associated with articular cartilage erosions in growing animals, especially dogs. FQs are not approved for use in skeletally immature puppies. Due to central inhibition at the -aminobutyric acid receptor, FQs, especially enrofloxacin, should be avoided in patients with a history of seizures.19
FQs interfere with hepatic clearance of theophylline, resulting in a prolonged half-life and the potential for theophylline toxicity.20
4. Doxycycline
Doxycycline is a bacteriostatic, lipophilic antibiotic capable of penetrating most tissues and fluids, including the prostate. Most of the drug is excreted in bile and/or feces.21
Doxycycline is the rational choice for treating canine prostatitis associated with a susceptible Staphylococcus spp or as part of combination therapy for Brucella canis. Broader use of doxycycline (or minocycline) in treating clinically significant bacteriuria is not recommended due to its limited spectrum of activity against common bacterial pathogens (eg, Escherichia coli, Klebsiella spp, Proteus spp, Pseudomonas spp, Enterococcus spp) and low urine concentrations.3 Doxycycline is also the treatment of choice for leptospirosis, as it eliminates leptospiremia and the carrier state.
The bioavailability of tetracyclines (eg, doxycycline, minocycline) is reduced in the presence of di- and trivalent cations (ie, dairy products, antacids, sucralfate).22,23 Tetracycline is routinely used as the class indicator for doxycycline susceptibility testing. Oral administration of doxycycline tablets is associated with esophagitis or esophageal strictures.24,25 Oral administration should be followed with food and/or water; alternatively, the drug can be compounded into a liquid.
Tetracyclines chelate calcium and inhibit calcification, which can cause deciduous tooth discoloration in young growing animals; caution should be used when treating puppies or kittens. Newer-generation tetracyclines (eg, doxycycline) have been reported to have a reduced affinity for calcium, which suggests a lower risk for tooth staining in human children.26
Increased liver enzymes have been reported in both dogs and cats treated with doxycycline.27 Canine hepatocyte cultures exposed to tetracyclines induce hepatocyte steatosis in vitro.28 GI upset may be minimized by administering tetracyclines with food.29
5. Chloramphenicol
Chloramphenicol distributes to most tissues, including the kidney and prostate. Most absorbed chloramphenicol is metabolized by the liver to inactive metabolites with limited urinary excretion of active drug (6%).30,31
Use of chloramphenicol should be reserved for the treatment of clinically significant bacteriuria (complicated or recurrent pyelonephritis or prostatitis) based on culture and susceptibility testing (eg, when a chloramphenicol-susceptible, multidrug-resistant pathogen has been isolated).
In dogs, GI upset is common.32 Increased liver enzymes and/or bone marrow suppression may occur with prolonged use. Chloramphenicol is a cytochrome P450 enzyme inhibitor (eg, CYP2B11) that decreases the clearance of substrate drugs, including methadone33,34 and propofol, in dogs.35 In humans, irreversible, life-threatening aplastic anemia is possible. To avoid accidental ingestion, owners should be cautioned and educated about the proper handling of tablets, including wearing gloves and washing hands.36
6. Nitrofurantoin
Nitrofurantoin limits bacterial growth via inhibition of bacterial enzymes. Despite limited antibiotic resistance to urinary pathogens, the pharmacokinetics and clinical side effects in dogs and cats limit routine use of nitrofurantoin. The drug is typically reserved for treating complicated infections supported by bacterial culture and susceptibility testing, such as multidrug-resistant lower urinary tract isolates that maintain in vitro susceptibility to nitrofurantoin (eg, extended-spectrum β-lactamase–producing E coli, methicillin-resistant S pseudintermedius).
Nitrofurantoin requires frequent (q8h) dosing in dogs (derived from human pharmacokinetic data).37 Nitrofurantoin is rapidly distributed and/or eliminated from canine plasma, which results in high urinary concentrations (Table 3).
Nitrofurantoin is most appropriate for treating lower UTIs. Because of its poor tissue penetration, nitrofurantoin is not effective in treating pyelonephritis or prostatitis.38
Side effects can include GI upset.39
In humans, nitrofurantoin use is contraindicated in patients with decreased renal function (ie, creatinine clearance cutoff <40-60 mL/min).40 Other adverse effects reported in humans include hepatopathy with a suspected immune-mediated mechanism41 and/or neurotoxicity (peripheral neuropathy most commonly described).42
Table 3: Comparative Antibiotic Concentrations Attains in Canine Urine vs. Serum
B-Lactums
Potentiated Sulfonamides
Fluoroquinolones
Tetracyclines
Amphenicols
Nitrofurans
PK data reported is estimated for each antibiotic class based on available canine data.
,Ampicillin breakpoint, used to predict susceptibility to amoxicillin
bCephalothin breakpoint, used to predict susceptibility to cephalexin
cTrimethoprim-sulfamethoxazole breakpoint, used to predict susceptibility to trimethoprim-sulfadiazine
HHuman interpretive breakpoint where appropriate
SSkin/soft tissue veterinary interpretive breakpoint
SRSkin/respiratory veterinary interpretive breakpoint
Conclusion
Clinical bacteriuria is among the most common veterinary conditions that require an antibiotic. In most cases, the initial antibiotic prescription is empirical while culture and susceptibility test results are pending. Antibiotic therapy alone may not be the only therapy needed for successful resolution of clinical bacteriuria; when possible, correction or treatment of contributing factors is equally important.
A rational approach to every antibiotic prescription requires the clinician to identify the indication, site of infection, targeted pathogen, and fluid and/or tissue needed for culture and susceptibility testing, as well as consideration of patient factors (eg, concurrent problems, current medications) that influence antibiotic selection. The increasing prevalence of resistant canine and feline urinary tract isolates7,43 makes the use of bacterial culture and antimicrobial susceptibility testing, even in patients anticipated to have uncomplicated infections, increasingly important early in the course of disease for clinical success and antimicrobial stewardship.
FQ = fluoroquinolone , MIC = minimum inhibitory concentration, TMP/sulfa = trimethoprim-sulfonamides